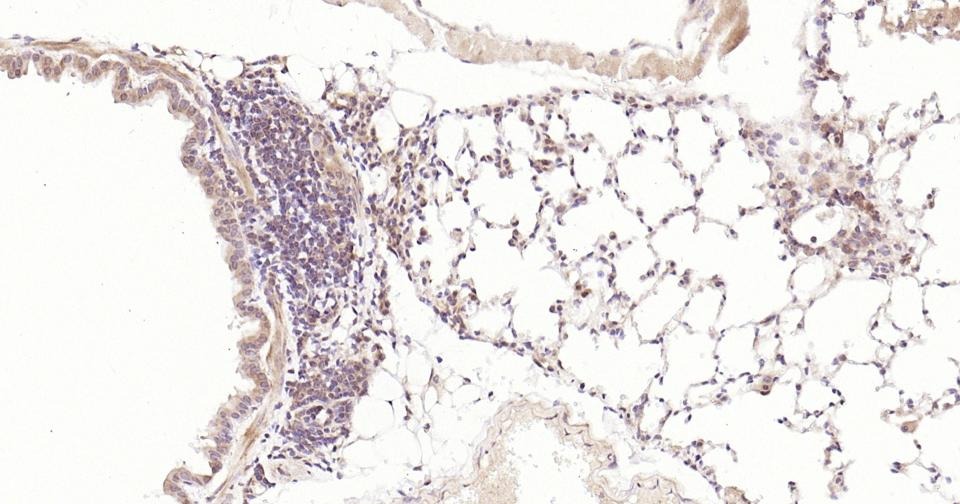

购物车
 您的购物车当前为空
您的购物车当前为空
Anti-STAT3 Antibody (3R504) 是一种 Rabbit 抗体,靶向 STAT3。Anti-STAT3 Antibody (3R504) 可用于 FCM, ICC/IF, IF, IHC-Fr, IHC-P, WB。
别名 signal transducer and activator of transcription 3 (acute-phase response factor), HIES, APRF, ADMIO
Anti-STAT3 Antibody (3R504) 是一种 Rabbit 抗体,靶向 STAT3。Anti-STAT3 Antibody (3R504) 可用于 FCM, ICC/IF, IF, IHC-Fr, IHC-P, WB。
| 规格 | 价格 | 库存 | 数量 |
|---|---|---|---|
| 25 μL | ¥ 785 | 5日内发货 | |
| 50 μL | ¥ 1,395 | 5日内发货 | |
| 100 μL | ¥ 2,485 | 5日内发货 |
TargetMol的所有产品仅用作科学研究或药证申报,不能被用于人体,我们不向个人提供产品和服务。请您遵守承诺用途,不得违反法律法规规定用于任何其他用途。
| 产品描述 | Anti-STAT3 Antibody (3R504) is a Rabbit antibody targeting STAT3. Anti-STAT3 Antibody (3R504) can be used in FCM, ICC/IF, IF, IHC-Fr, IHC-P, WB. |
| 别名 | signal transducer and activator of transcription 3 (acute-phase response factor), HIES, APRF, ADMIO |
| Ig Type | IgG |
| 克隆号 | 3R504 |
| 反应种属 | Human,Mouse,Rat |
| 验证活性 | 1. 25 μg total protein per Lane of various lysates probed with STAT3 monoclonal antibody, unconjugated (TMAB-01787) at 1:5000 dilution and 4°C overnight incubation. Followed by conjugated secondary antibody incubation at RT for 60 min. 2. Paraformaldehyde-fixed, paraffin embedded Mouse Lung; Antigen retrieval by boiling in sodium citrate buffer (pH6.0) for 15 min; Antibody incubation with STAT3 Monoclonal Antibody, Unconjugated (TMAB-01787) at 1:200 overnight at 4°C, followed by conjugation to the secondary antibody and DAB staining. 3. Paraformaldehyde-fixed, paraffin embedded Rat Lung; Antigen retrieval by boiling in sodium citrate buffer (pH6.0) for 15 min; Antibody incubation with STAT3 Monoclonal Antibody, Unconjugated (TMAB-01787) at 1:200 overnight at 4°C, followed by conjugation to the secondary antibody and DAB staining. 4. Paraformaldehyde-fixed, paraffin embedded Mouse Cerebrum; Antigen retrieval by boiling in sodium citrate buffer (pH6.0) for 15 min; Antibody incubation with STAT3 Monoclonal Antibody, Unconjugated (TMAB-01787) at 1:200 overnight at 4°C, followed by conjugation to the secondary antibody and DAB staining. 5. Paraformaldehyde-fixed, paraffin embedded Rat Cerebrum; Antigen retrieval by boiling in sodium citrate buffer (pH6.0) for 15 min; Antibody incubation with STAT3 Monoclonal Antibody, Unconjugated (TMAB-01787) at 1:200 overnight at 4°C, followed by conjugation to the secondary antibody and DAB staining. 6. Paraformaldehyde-fixed, paraffin embedded Mouse Pancreas; Antigen retrieval by boiling in sodium citrate buffer (pH6.0) for 15 min; Antibody incubation with STAT3 Monoclonal Antibody, Unconjugated (TMAB-01787) at 1:200 overnight at 4°C, followed by conjugation to the secondary antibody and DAB staining. 7. Paraformaldehyde-fixed, paraffin embedded Rat Pancreas; Antigen retrieval by boiling in sodium citrate buffer (pH6.0) for 15 min; Antibody incubation with STAT3 Monoclonal Antibody, Unconjugated (TMAB-01787) at 1:200 overnight at 4°C, followed by conjugation to the secondary antibody and DAB staining. 8. Paraformaldehyde-fixed, paraffin embedded Human Pancreatic Cancer; Antigen retrieval by boiling in sodium citrate buffer (pH6.0) for 15 min; Antibody incubation with STAT3 Monoclonal Antibody, Unconjugated (TMAB-01787) at 1:200 overnight at 4°C, followed by conjugation to the secondary antibody and DAB staining. 9. Paraformaldehyde-fixed, paraffin embedded Human Cervical Cancer; Antigen retrieval by boiling in sodium citrate buffer (pH6.0) for 15 min; Antibody incubation with STAT3 Monoclonal Antibody, Unconjugated (TMAB-01787) at 1:200 overnight at 4°C, followed by conjugation to the secondary antibody and DAB staining. 10. Paraformaldehyde-fixed, paraffin embedded Human Breast Cancer; Antigen retrieval by boiling in sodium citrate buffer (pH6.0) for 15 min; Antibody incubation with STAT3 Monoclonal Antibody, Unconjugated (TMAB-01787) at 1:200 overnight at 4°C, followed by conjugation to the secondary antibody and DAB staining. 11. Paraformaldehyde-fixed, paraffin embedded Human Kidney Cancer; Antigen retrieval by boiling in sodium citrate buffer (pH6.0) for 15 min; Antibody incubation with STAT3 Monoclonal Antibody, Unconjugated (TMAB-01787) at 1:200 overnight at 4°C, followed by conjugation to the secondary antibody and DAB staining. 12. Paraformaldehyde-fixed, paraffin embedded Human Kidney; Antigen retrieval by boiling in sodium citrate buffer (pH6.0) for 15 min; Antibody incubation with STAT3 Monoclonal Antibody, Unconjugated (TMAB-01787) at 1:200 overnight at 4°C, followed by conjugation to the secondary antibody and DAB staining. 13. 25 μg total protein per Lane of various lysates probed with STAT3 monoclonal antibody, unconjugated (TMAB-01787) at 1:1000 dilution and 4°C overnight incubation. Followed by conjugated secondary antibody incubation at RT for 60 min. 14. The Hela (H) cells were fixed with 4% PFA (10 min at room temperature) and then permeabilized with 90% ice-cold methanol for 20 min at-20°C,the cells then were incubated in 5% BSA to block non-specific protein-protein interactions (30 min at room temperature). Primary Antibody (green): Rabbit Anti-STAT3 antibody (TMAB-01787): 1:50-100/10^6 cells; Secondary Antibody (white blue): Goat anti-Rabbit IgG-BF488: 1 μg/test. Isotype Control (orange): Rabbit IgG. Blank control (black): PBS. |
| 应用 | FCMICC/IFIFIHC-FrIHC-PWB |
| 推荐剂量 | FCM=1:50-100; ICC/IF=1:50-200; IF=1:100-500; IHC-Fr=1:100-500; IHC-P=1:100-500; WB=1:1000-5000 |
| 抗体种类 | Monoclonal |
| 宿主来源 | Rabbit |
| 亚细胞定位 | Cytoplasm. Nucleus. Note=Shuttles between the nucleus and the cytoplasm. Translocated into the nucleus upon tyrosine phosphorylation and dimerization, in response to signaling by activated FGFR1, FGFR2, FGFR3 or FGFR4. Constitutive nuclear presence is independent of tyrosine phosphorylation. Predominantly present in the cytoplasm without stimuli. Upon leukemia inhibitory factor (LIF) stimulation, accumulates in the nucleus. The complex composed of BART and ARL2 plays an important role in the nuclear translocation and retention of STAT3. Identified in a complex with LYN and PAG1. |
| 组织特异性 | Heart, brain, placenta, lung, liver, skeletal muscle, kidney and pancreas. |
| 构建方式 | Recombinant Antibody |
| 纯化方式 | Protein A purified |
| 性状 | Liquid |
| 缓冲液 | 0.01M TBS (pH7.4) with 1% BSA, 0.02% Proclin300 and 50% Glycerol. |
| 浓度 | 1 mg/mL |
| 研究背景 | The protein encoded by this gene is a member of the STAT protein family. In response to cytokines and growth factors, STAT family members are phosphorylated by the receptor associated kinases, and then form homo- or heterodimers that translocate to the cell nucleus where they act as transcription activators. This protein is activated through phosphorylation in response to various cytokines and growth factors including IFNs, EGF, IL5, IL6, HGF, LIF and BMP2. This protein mediates the expression of a variety of genes in response to cell stimuli, and thus plays a key role in many cellular processes such as cell growth and apoptosis. The small GTPase Rac1 has been shown to bind and regulate the activity of this protein. PIAS3 protein is a specific inhibitor of this protein. Mutations in this gene are associated with infantile-onset multisystem autoimmune disease and hyper-immunoglobulin E syndrome. Alternative splicing results in multiple transcript variants encoding distinct isoforms. [provided by RefSeq, Sep 2015] |
| 免疫原 | A synthesized peptide: human STAT3 |
| 抗原种属 | Human |
| 基因名称 | STAT3 |
| 基因ID | |
| 蛋白名称 | Signal transducer and activator of transcription 3 |
| Uniprot ID | |
| 研究领域 | STAT family,Transcription factors/regulators,Transcription factors,Surface molecules,STATs,Other factors,SARS Coronavirus,STATs,Intracellular |
| 功能 | Transcription factor that binds to the interleukin-6 (IL-6)-responsive elements identified in the promoters of various acute-phase protein genes. Activated by IL31 through IL31RA. |
| 分子量 | Theoretical: 88 kDa. Actual: 85 kDa. |
| 储存方式 | Store at -20°C or -80°C for 12 months. Avoid repeated freeze-thaw cycles. |
| 运输方式 | Shipping with blue ice. |